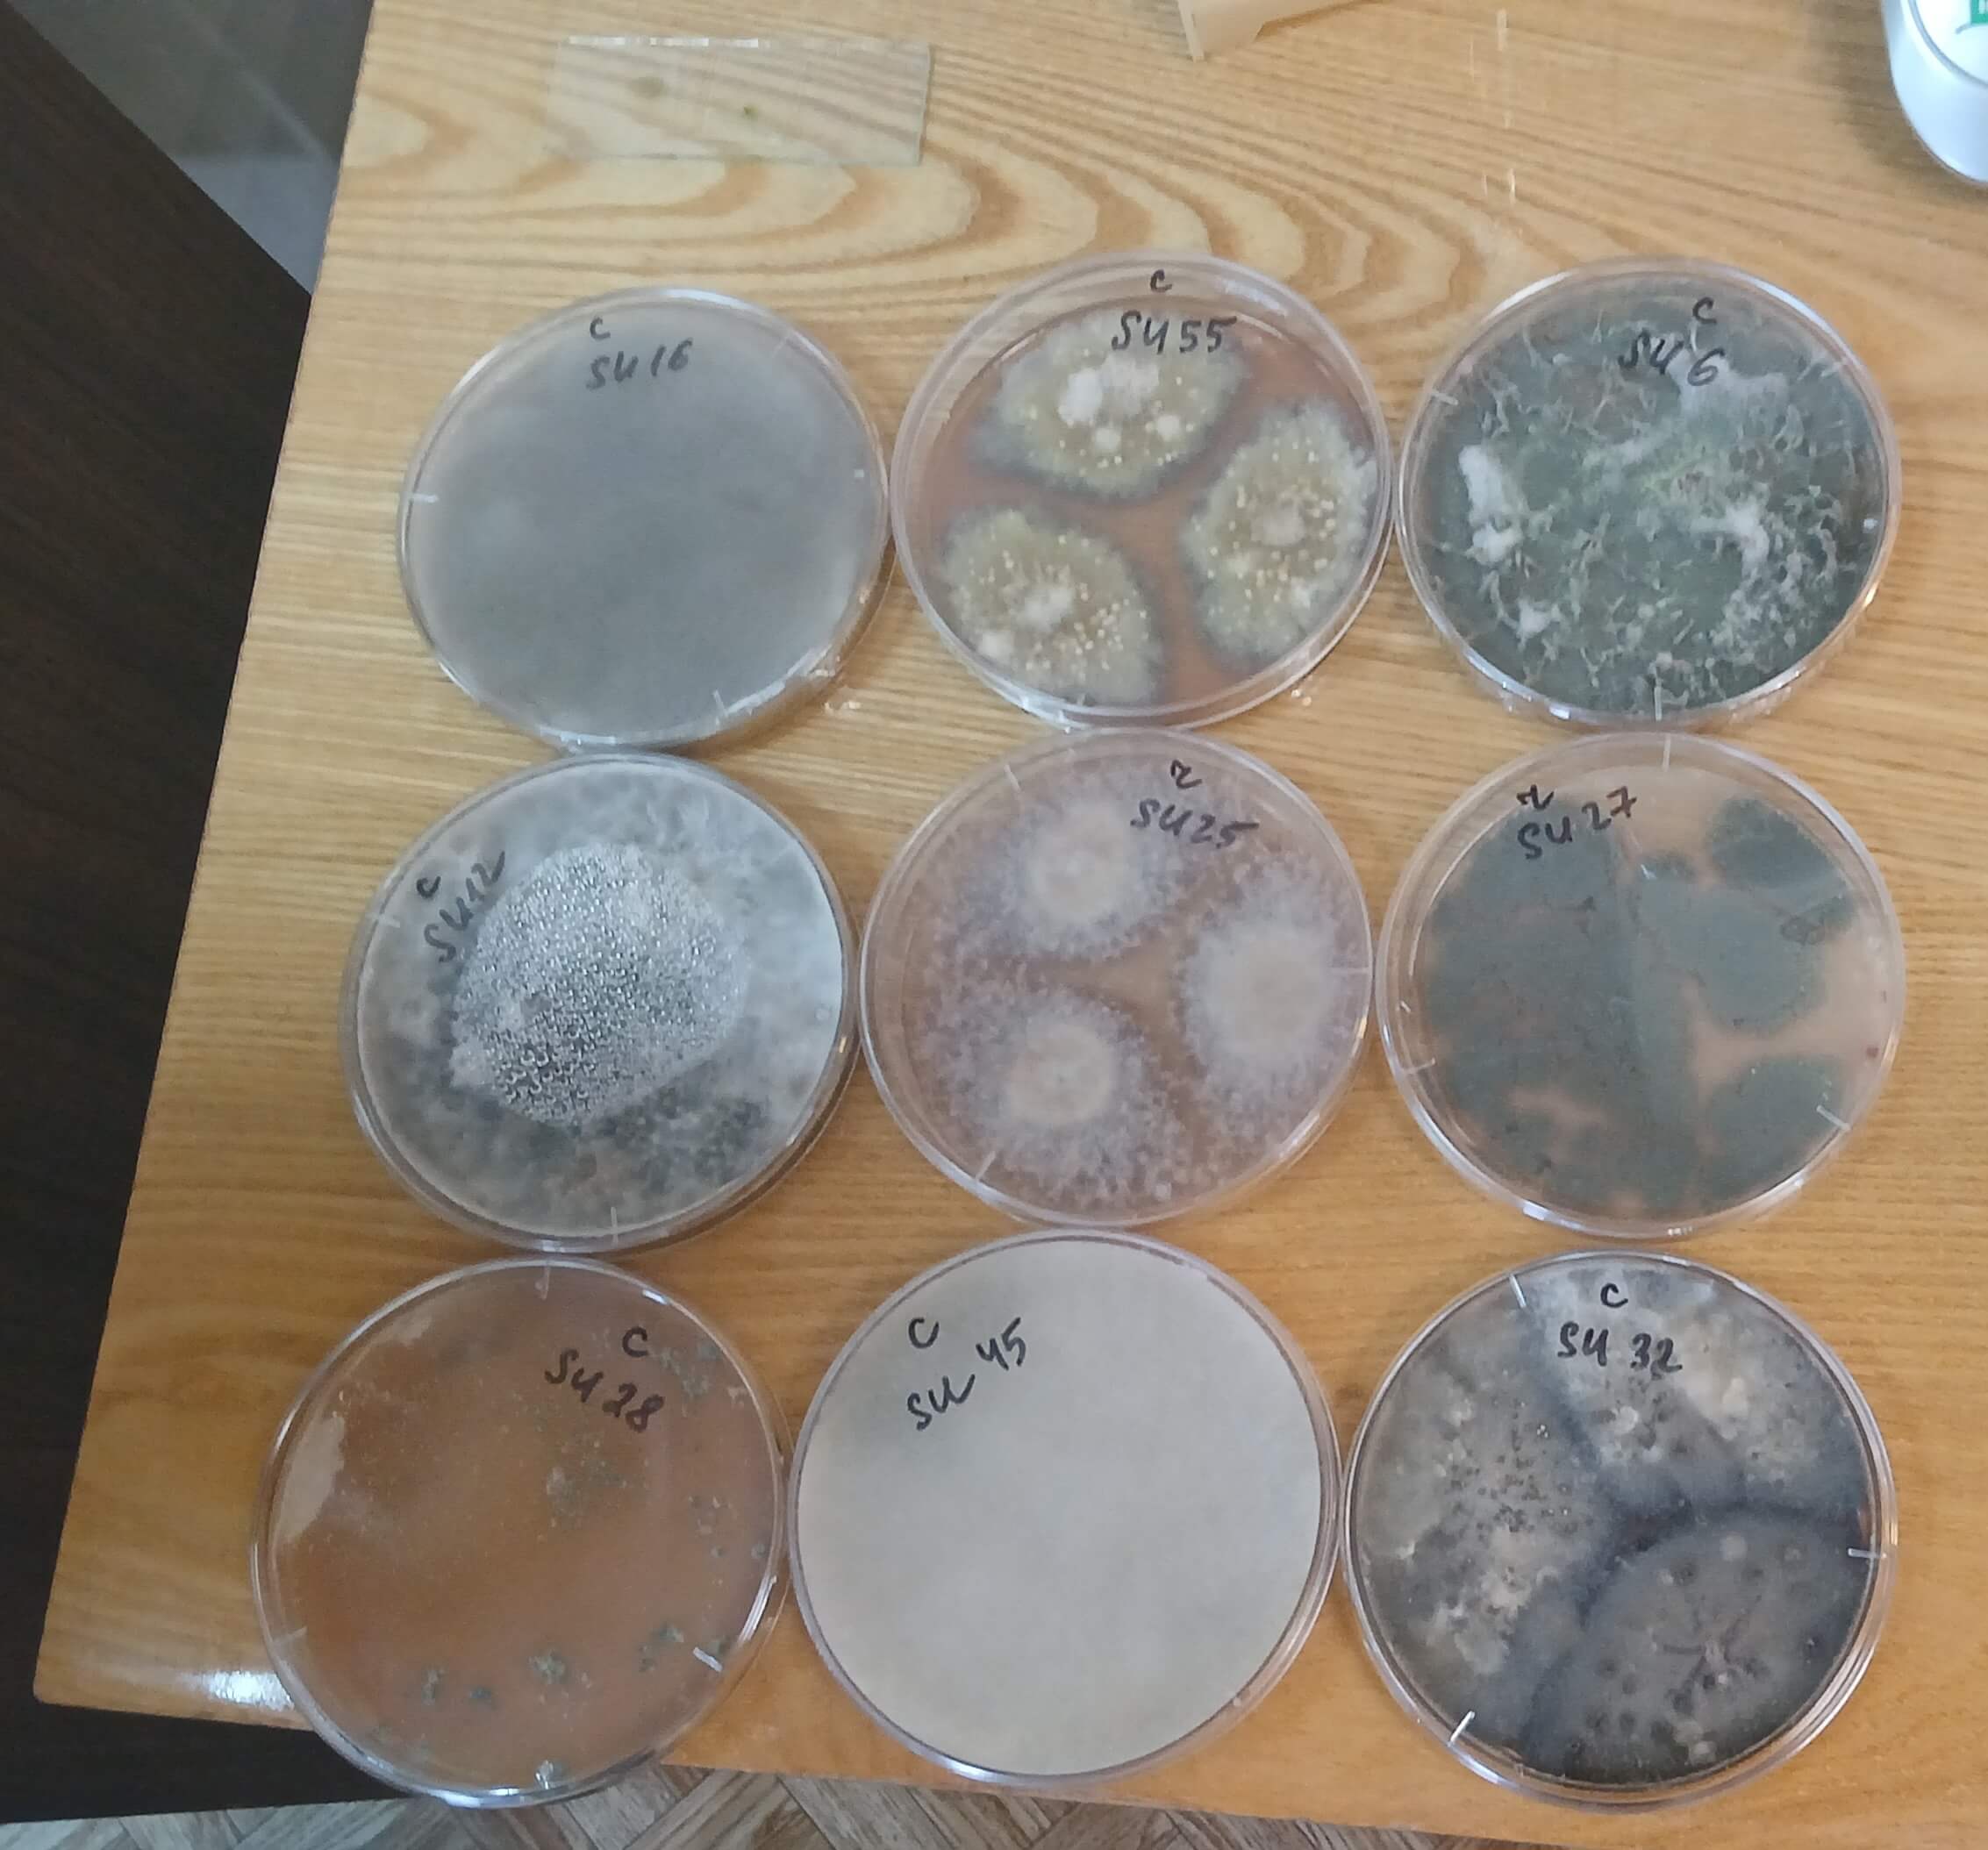

Микробы, грибы и микроскопы: как студенты-биофизики знакомились с профессией
В преддверии Дня микробиолога (15 апреля) студенты 1 курса образовательной программы «Биология: Биофизика» вместе с доцентом кафедры физики, биологии и инженерных технологий Любовью Александровной Бобревой отправились на экскурсию. Место встречи — лаборатория экологии микроорганизмов № 27 Института проблем промышленной экологии Севера КНЦ РАН.
Экскурсия стала не просто частью учебной программы, а настоящим погружением в реальные задачи современной микробиологии.
Что успели сделать будущие биофизики:
- Узнали о ключевых направлениях работы лаборатории
- Познакомились с профессиональным оборудованием
- Самостоятельно провели биохимические тесты по идентификации микроорганизмов
- Изучили микроморфологию грибов с помощью современного микроскопа
- Научились определять род и вид исследуемых объектов — теория сразу перешла в практику!
Сами студенты признались: экскурсия позволила им не просто расширить кругозор, а почувствовать себя настоящими исследователями. А это дорогого стоит.
Такие выездные занятия помогают формировать профессиональное сообщество и укрепляют интерес к будущей профессии. Спасибо коллективу ИППЭС КНЦ РАН за увлекательную встречу и тёплый приём!